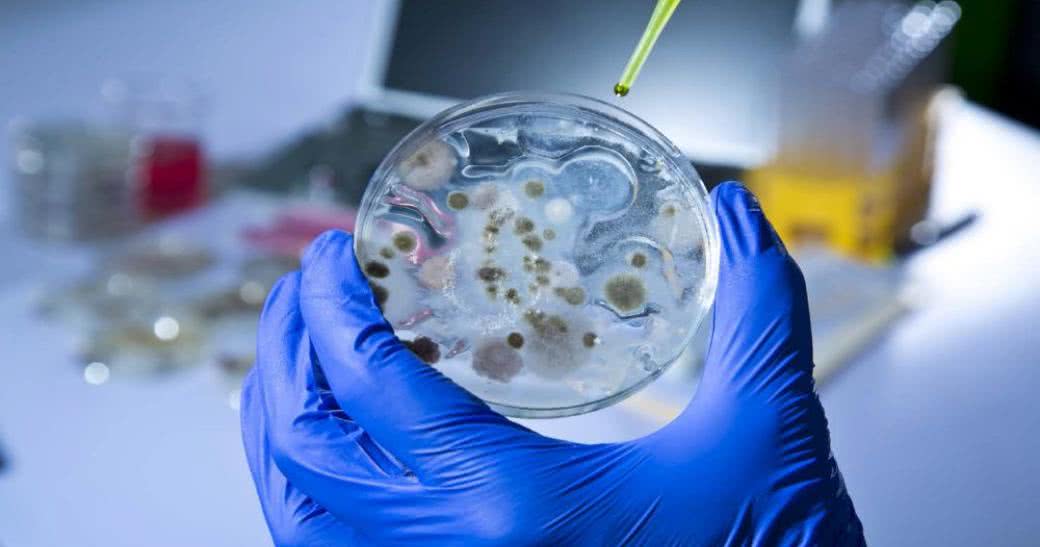

Właśnie spełniły się najczarniejsze przewidywania co do skuteczności antybiotyków - bakteria oporna na wszystkie antybiotyki jest już w polskich szpitalach. U kilkuset pacjentów stwierdzono Klebsiella pneumoniae NDM. Lekarze obawiają się, że znalezienie leku, który by sobie z nią poradził, może zająć kilka lat.
Bakteria Klebsiella pneumoniae NDM posiada gen NDM-1 - New Delhi-Metallo-beta-laktam-1 - kodujący enzymy (przede wszystkim metalo-beta-laktamazy), które unieszkodliwiają praktycznie wszystkie antybiotyki, nawet te ostatniej szansy, stosowane w leczeniu ciężko chorych. Brytyjscy naukowcy z Uniwersytetu w Cardiff wykryli gen NDM-1 w 2009 r. u Szweda, który leczył się w Indiach (stąd wzięła się nazwa New Delhi).
Dlaczego bakteria jest taka groźna? Klebsiella pneumoniae typu NDM nie tylko nie poddaje się działaniu antybiotyków, ale też bardzo łatwo przenosi się z człowieka na człowieka i, co gorsza, potrafi przekazywać gen oporności innym mikrobom, w tym powszechnie występującej Escherichia coli.
Infekcje wywołane przez pałeczki Klebsiella trudno leczyć, a choroba ma często bardzo gwałtowny przebieg. Dzieje się tak z powodu szczególnych właściwości tych bakterii. Mają one grubą, wielocukrową otoczkę, która utrudnia fagocytozę, czyli wchłonięcie ich przez komórki układu odpornościowego zwalczające infekcje.
Rzecznik Głównego Inspektoratu Sanitarnego Jan Bondar przyznaje, że rozprzestrzenianie się w polskich szpitalach New Delhi może być efektem zaniedbań, m.in. w zakresie sterylności wśród personelu medycznego. Jego zdaniem wiele szpitali, będąc pod presją bieżących oszczędności, tnie wydatki związane z utrzymaniem higieny. Poza tym w placówkach brakuje izolatek, a personel nie został przeszkolony, by radzić sobie z problemem szerzących się bakterii.
Od wielu lat antybiotyki uważane są za najskuteczniejsze preparaty w leczeniu infekcji bakteryjnych. Teraz, gdy okazuje się, że mikroby nauczyły się przed nimi bronić, czujemy się bezradni. Po ponad 70 latach hegemonii potomków penicyliny trudno sobie wyobrazić, że może nas zabić byle infekcja. Tymczasem według WHO antybiotykooporność jest jednym z największych zagrożeń dla ludzkiego zdrowia.
W krajach Unii Europejskiej z powodu zakażeń bakteriami opornymi na antybiotyki rocznie umiera ok. 25 tys. pacjentów!
Podbramkowa sytuacja zmusza naukowców do niekonwencjonalnych działań. Odkopują stare badania, które wynalezienie penicyliny zepchnęło do lamusa. Szukają też nowych rozwiązań.
Na ironię zakrawa fakt, że autorem jednego z rozwiązań jest odkrywca pierwszego antybiotyku Alexander Fleming. Na kilka lat przed odkryciem penicyliny, w 1922 r., przeziębiony naukowiec siedział nad preparatami z bakteriami i na płytkę trafiła kropla kataru. Po kilkunastu dniach Fleming ze zdziwieniem stwierdził, że katar rozpuścił mikroby. Powtórzył doświadczenie ze łzami. I tym razem okazało się, że jedna ich kropla rozpuszczała kolonie w probówce w czasie nawet poniżej 5 sekund. Tak doszło do odkrycia lizozymu (enzymu litycznego), stanowiącego naturalny antyseptyk¹.
Dziś zapomniana praca wraca do łask. Enzymy lityczne przyczepiają się do zewnętrznej błony komórkowej bakterii i przebijają ją. Wewnętrzne ciśnienie dopełnia działania, powodując rozerwanie i śmierć komórki bakterii. Co istotne, enzymy lityczne działają wybiórczo na określone rodzaje bakterii, w przeciwieństwie do antybiotyków, które są bronią totalną. Enzymy lityczne pozwoliłyby zatem na terapie celowane, bez niszczenia przyjaznej flory bakteryjnej. Biolodzy i biochemicy z Georgia Institute of Technology oraz z University of Maryland opracowują katalog oddziaływań enzymów litycznych pochodzących z wielu źródeł na różnorakie szczepy bakterii, mając nadzieję, że nowa broń pozwoli zwalczyć bakterie z genem NDM-1².
Profesor Yiannis Samaras i dr Effimia Eriotou z Instytutu Edukacji Technologicznej Wysp Jońskich testowali aktywność mikrobiologiczną 8 roślinnych olejków eterycznych. Stwierdzili, że najskuteczniejszy był olejek tymiankowy, który w ciągu godziny eliminował niemal wszystkie bakterie. Olejki tymiankowy i cynamonowy okazały się najefektywniejszą bronią przeciwko gronkowcom (Staphylococcus). Choć są one wykorzystywane w medycynie od setek lat, nadal niewiele wiadomo o mechanizmach ich działania³.
Z kolei egipscy badacze ogłosili, że zielona herbata wzmacnia działanie antybiotyków, a co istotne - w 20% przypadków pozwalała wywołać wrażliwość bakterii na preparaty, na które były one wcześniej oporne4.
Bibliografia
- http://goo.gl/7c6iHh
- Gabriel J Mitchell, Daniel C Nelson, Joshua S Weitz, Quantifying enzymatic lysis: estimating the combined effects of chemistry, physiology and physics, 2010 IOP Publishing Ltd; Physical Biology, Volume 7, Number 4
- https://goo.gl/5hqnBg
- Dr Mervat Kassem from the Faculty of Pharmacy at Alexandria University in Egypt at the Society for General Microbiology’s 162nd meeting, Monday 31 March 2008
- http://goo.gl/8MVYuX
- http://goo.gl/GKHxHM
Zdaniem australijskich ekspertów syntetyczny cukier oparty na zmodyfikowanej wersji własnych cukrów bakterii może być skutecznym środkiem przeciwko opornym na zwykłe antybiotyki mikrobom. - Błony komórkowe bakterii swoją strukturą przypominają murowaną ścianę, w której spoiwem dla poszczególnych "cegieł" są cukrowe polimery. Dodatek zmodyfikowanego cukru sprawia, że zaprawa przestaje trzymać, błona komórkowa się rozpada i bakteria ginie - wyjaśnia kierujący pracami zespołu prof. Matt Cooper z australijskiego University of Queensland5.
Brytyjczycy pracują nad nanofarbą, która po włączeniu ultrafioletu może zabijać lekooporne superbakterie. Byłoby to doskonałe rozwiązanie dla szpitali. Farba zawiera mikrocząsteczki tlenku tytanu (IV), który charakteryzuje się wysoką absorpcją w zakresie promieniowania ultrafioletowego. Powstają wtedy aktywne cząsteczki, oczyszczające pomalowane powierzchnie6.

 Nasze magazyny
Nasze magazyny